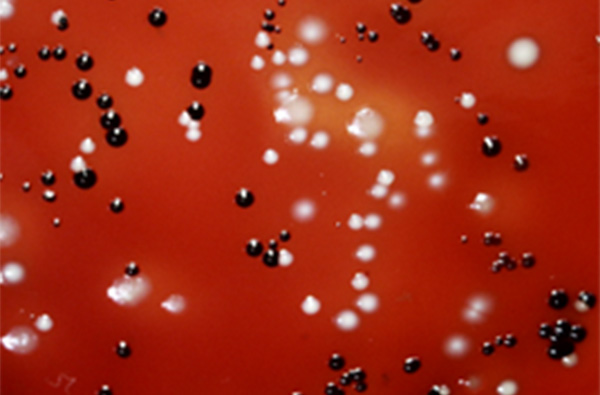
微生物学講座の教育

講座の特徴
Feature

微生物学講座では、う蝕や歯周病の原因となる口腔内微生物を中心に、口腔と全身をつなぐマイクロバイオームの役割を研究しています。
口腔内に共存する多様な細菌のバランスが崩れると、口腔疾患だけでなく、心血管系疾患や糖尿病などの全身疾患にも影響を及ぼします。
私たちは「口腔の健康は全身の健康につながる」という考えのもと、口腔疾患予防に資する研究と人材育成を通じて、社会への貢献を目指しています。
教育
Education
微生物学講座では、病原体がどのようにして病気を引き起こすのか、そして私たちの体がどのように病原体から身を守っているのかを軸に、一般感染症、免疫学について講義を行っています。
2年次では、一般感染症の分野で病原体がもつ病原因子の働きを学び、免疫学では体内の防御機構がどのように感染を防いでいるのかを理解します。これにより、「感染症」と「生体防御」という2つの視点から、感染症全体の仕組みを体系的に学びます。
3年次になると、口腔という特殊な環境に注目し、口腔に存在している多数の細菌のあつまり、口腔マイクロバイオームの特徴や、ディスバイオーシスによって、う蝕や歯周病がどのように発症するのかを、講義と実習を通して学びます。また口腔内細菌と全身疾患の関係についても講義を通じて学びます。
これらの学びを通じて、最新の感染症に関する知識と適切な感染防御法を身につけ、口腔疾患の予防や治療を科学的に考え、実践できる歯科医師としての基礎力を養うことを目指しています。
研究
Research


口腔内には健康な状態でも多様な細菌が共存しており、歯周病の発症・進行の仕組みは未だ十分に解明されていません。微生物学講座では、マイクロバイオーム解析を中心に、歯周病原細菌の病原因子や細菌間相互作用、生体防御反応との関係を解析し、歯周炎の病因解明に取り組んでいます。
これらの研究成果を基盤として、歯周炎の予防法の確立と、口腔から全身の健康、さらには健康長寿への貢献を目標に、研究を推進しています。
